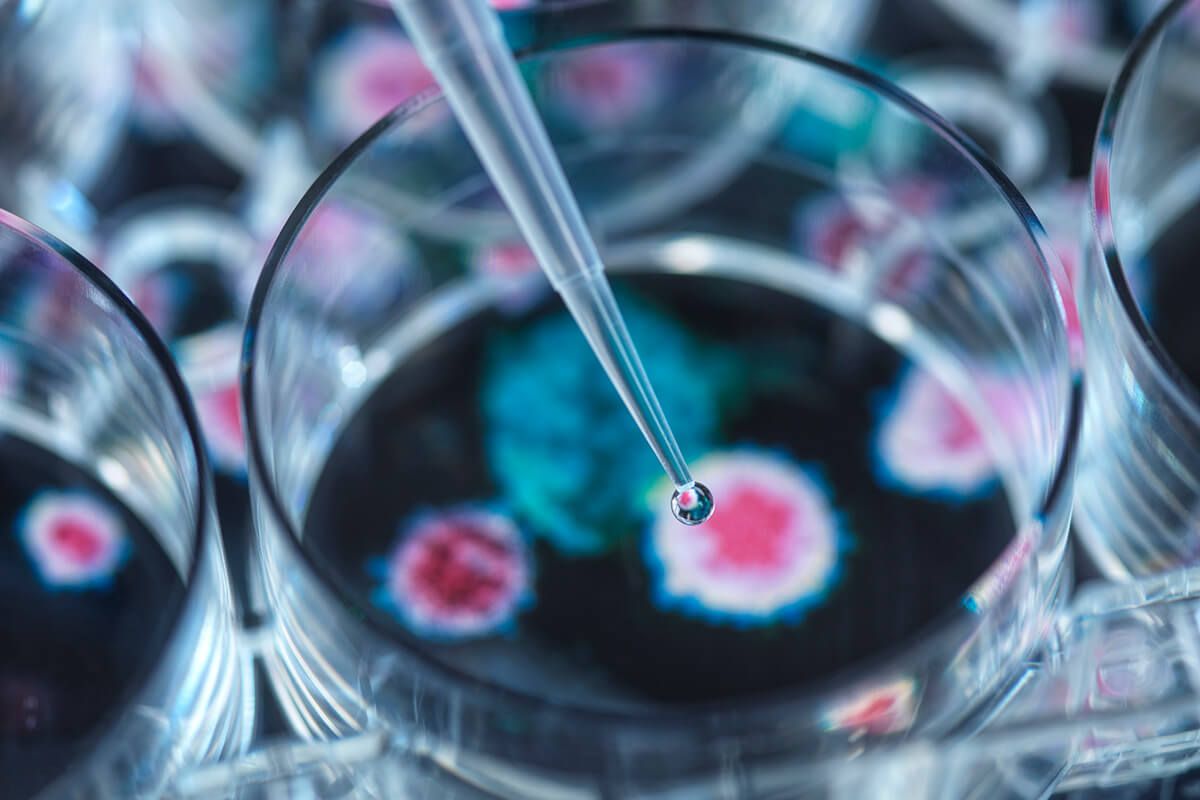

Человеческий организм за свою жизнь подвергается множеству угроз. Наиболее частыми и распространенными из них являются вирусные и бактериальные заболевания. С ними приходится сталкиваться как грудничкам, так и взрослым. Для успешного лечения необходимо сразу определить природу заболевания. Как же отличить вирусную инфекцию от бактериальной?
Вирусы внедряются в живые клетки других организмов и активно размножаются, вызывая различные патологии. Наиболее часто людям приходится сталкиваться с инфекциями верхних дыхательных путей, которые принято называть простудными. Ученые открывают новые разновидности вирусов каждый день. На сегодняшний день их число перевалило за десятки тысяч. Несмотря на это, существует целый ряд отличительных признаков вирусного заболевания.
Основное отличие вируса – быстротечность. Инкубационный период таких заболеваний редко составляет более трех дней. Как правило, первые симптомы проявляются уже через 8-12 часов. Большинство вирусных заболеваний сопровождается повышением температуры, сильной ломотой в суставах, слабостью, сонливостью, головной болью. Нередко самочувствие ухудшается кашлем, заложенностью носа, раздражением слизистых. Многие вирусные заболевания сопровождаются рвотой, тошнотой, поносом и другими симптомами интоксикации. В некоторых случаях кожные покровы покрываются сыпью. Даже при отсутствии должного лечения, симптомы вирусной инфекции сохраняются на протяжении 7-10 дней.
Конечно же, не каждый вирус характеризуется всеми перечисленными признаками. Однако у всех заболеваний этой природы наблюдается быстротечность развития и затухание основных симптомов на 4-5 сутки.
Бактерий в природе насчитывает гораздо больше, чем вирусов. Науке уже известно более миллиона подобных одноклеточных организмов. Негативное влияние на здоровье человека оказывают бактерии из группы патогенных или болезнетворных. Именно они паразитируют в теле человека, отравляя его отходами жизнедеятельности. Все инфекции, имеющие бактериальную природу, характеризуются локализованными болевыми ощущениями. Инкубационный период может составлять от двух до 12 дней. Заболевания бактериальной природы сопровождаются субфебрильной температурой, налетом на слизистых, гнойными выделениями, снижением аппетита и вялостью. Симптомы могут наблюдаться в равной мере на протяжении двух недель. Без должного лечения болезнь переходит в острую форму. Обязательным назначением при бактериальном заражении является антибиотик.
Для выявления природы заболевания врач назначает общий анализ крови. При вирусном заболевании число лейкоцитов в крови и СОЭ находятся в норме или немного снижены. Лимфоциты и моноциты, напротив, повышены. При бактериальной инфекции показатели иные. Анализ крови покажет повышение СОЭ и количества лейкоцитов, снижение лимфоцитов и наличие метамиелоцитов, миелоцитов.
Выводы:
- Бактерий в природе насчитывает гораздо больше, чем вирусов.
- Вирусные заболевания развиваются гораздо быстрее, чем бактериальные.
- Большинство вирусных заболеваний сопровождается повышением температуры, сильной ломотой в суставах.
- Бактериальные заболевания характеризуются локализованными болевыми ощущениями.
- Заболевания бактериальной природы могут сопровождаться гнойными выделениями и налетом.
- Вирусные заболевания проходят даже без лечения, бактериальные – нет.
- При вирусных заболеваниях антибиотики бесполезны, при бактериальных – обязательны.
- Определить природу заболевания можно по анализу крови.